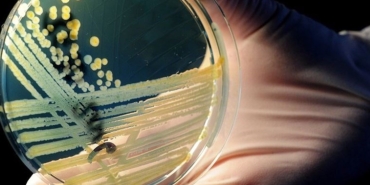
antimikrobiyal-direnc-nedir-antimikrobiyal-direncin-nedenleri-nelerdir-antimikrobiyal-direnc-nasil-onlenir-iHBVE7uc.jpg

Siyaset Haberleri
Spor Haberleri
Ekonomi Haberleri
Dünya Haberleri
Son Dakika Haberleri
22:51
22:51

Tv Aktuel
Köprüyü geçinceye kadar ayıya dayı derler atasözünün manası nedir?
16 Şubat 2025 - Paz - 22:51
22:51
22:51
22:51

Tv Aktuel
Koyun can kederinde kasap yağ kaygısında atasözünün manası nedir?
16 Şubat 2025 - Paz - 22:51
22:51
22:50

Sağlık
Erkeklerde en çok görülen kanser tipi: Akciğer kanserinden birincil korunma tekniği nedir?
16 Şubat 2025 - Paz - 22:50
Daha fazla gösterilecek yazı bulunamadı!
Tekrar deneyiniz.